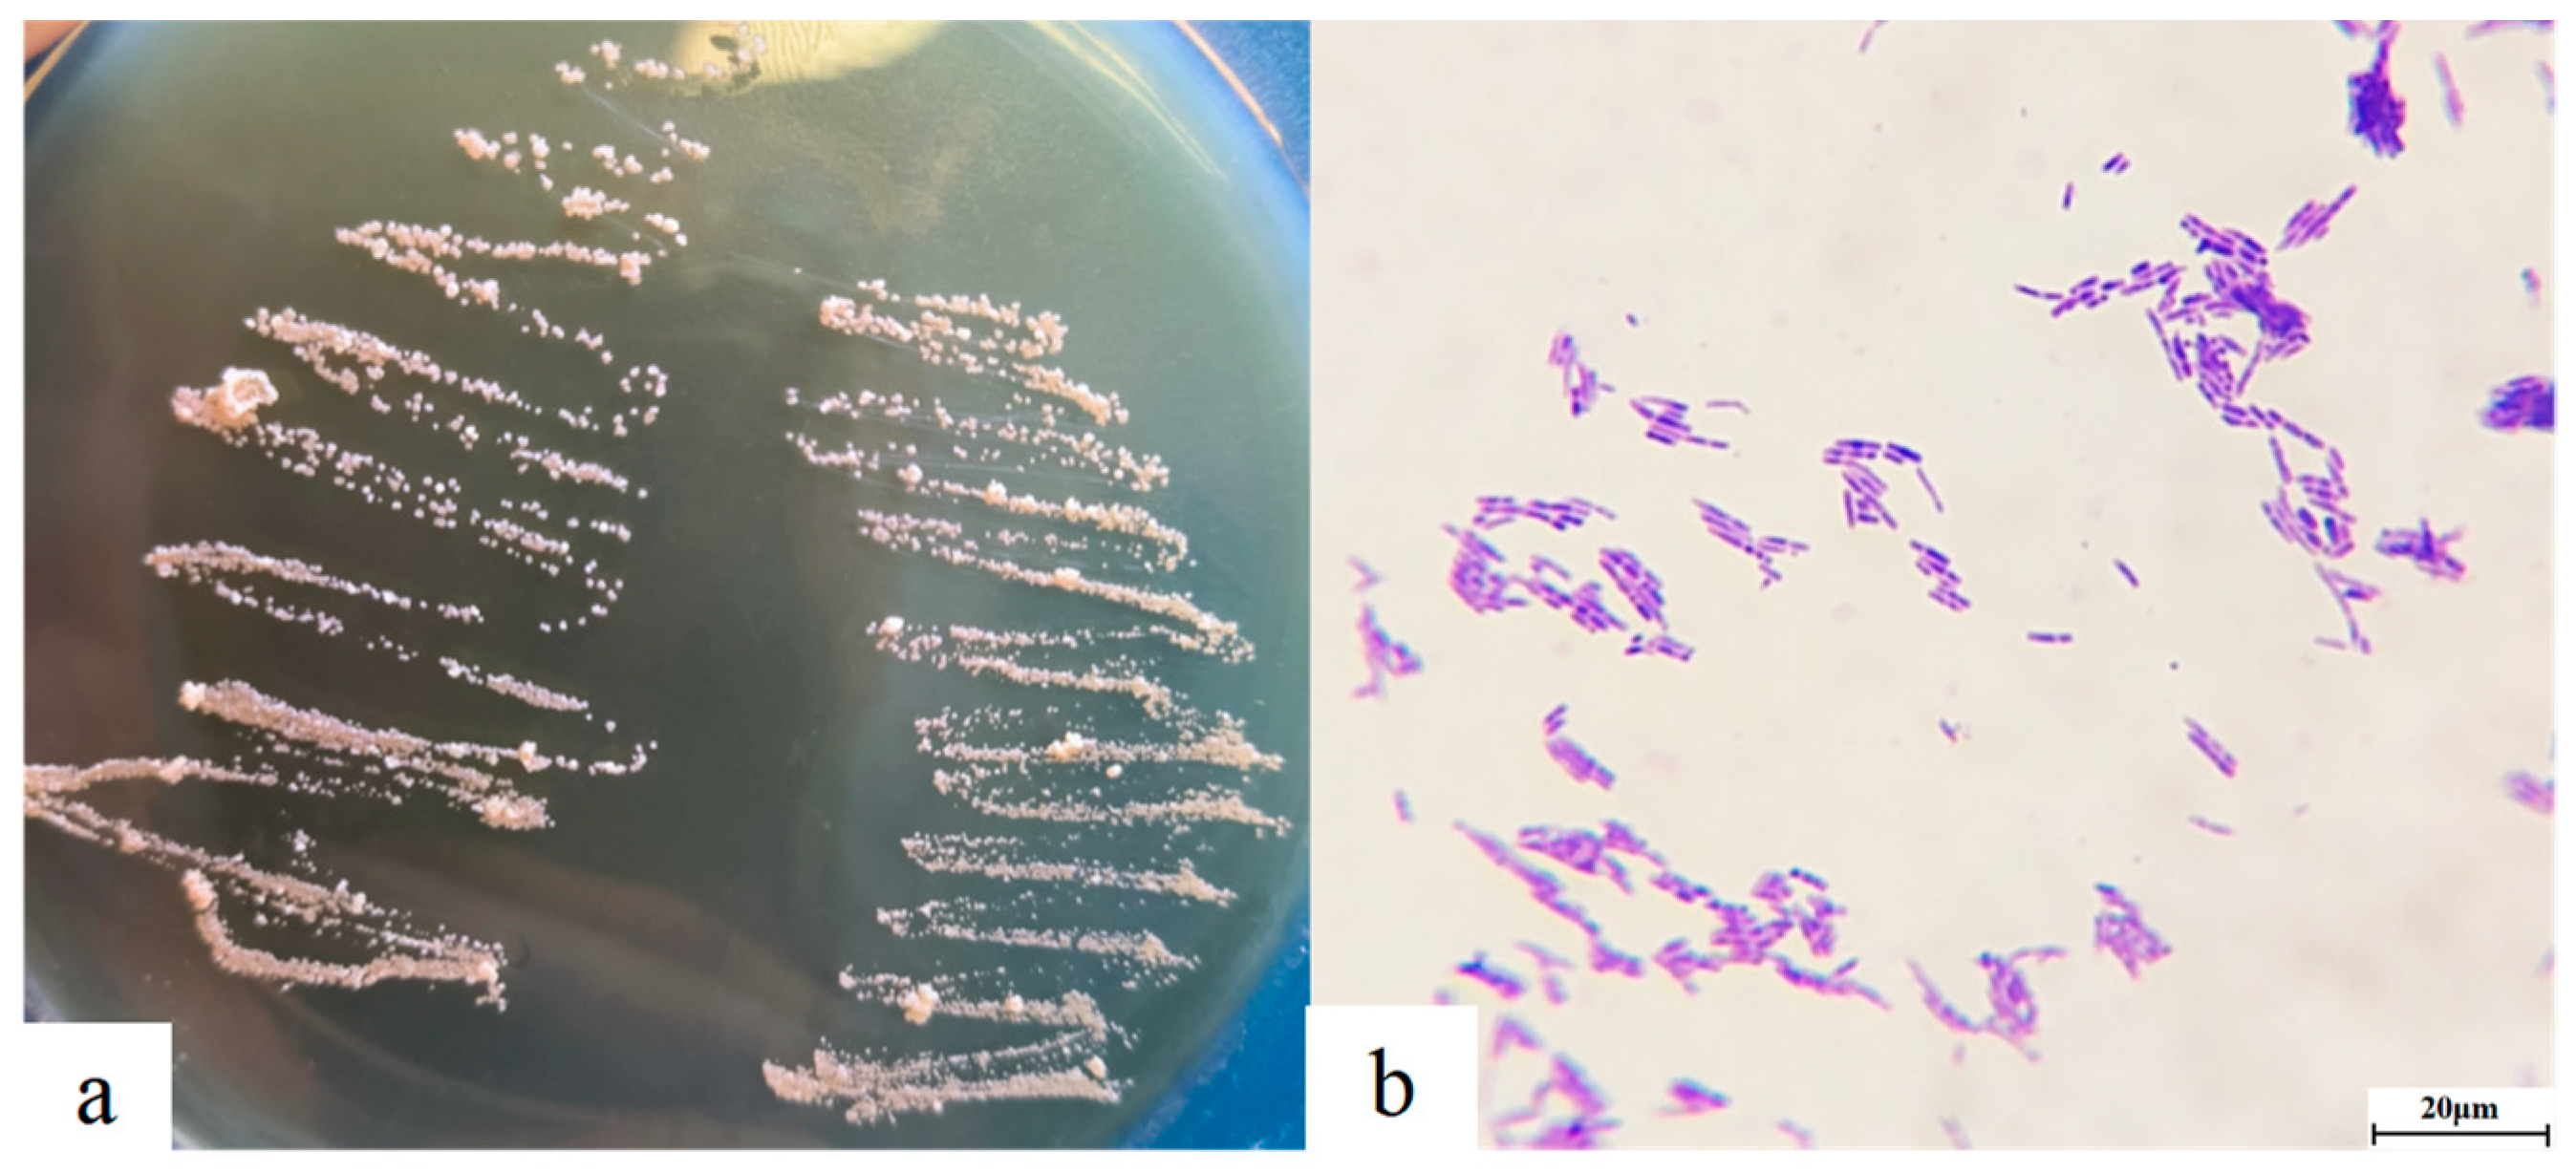

Pathological Progress of Two Types of Nodules in Micropterus salmoides Infected with Nocardia seriolae
Abstract
1. Introduction
2. Materials and Methods
2.1. Experimental Fish and Feeding
2.2. Isolation and Identification of Pathogens
2.3. Preliminary Infection Experiment
2.4. Dynamic Infection Model Construction
2.5. Gross Pathology Observation—Disease Stage Classification
2.6. Histopathological Observation
2.7. Ultrastructural Pathological Observation
2.8. Pathological Scoring
3. Results
3.1. Bacterial Isolation and Identification
3.2. The Clinical Manifestations in Preliminary Infection
3.3. Gross Pathological Observation—Disease Stage Classification
3.4. Histopathological and Ultrastructural Pathological Changes
3.5. Results of Pathological Scoring
4. Discussion
5. Conclusions
Author Contributions
Funding
Institutional Review Board Statement
Informed Consent Statement
Data Availability Statement
Acknowledgments
Conflicts of Interest
References
- Ministry of Agriculture And Rural Affairs Fisheries Administration Bureau, National Aquatic Product Technology Extension. China Fishery Statistical Yearbook; Agricultural Press of China: Beijing, China, 2024; p. 25. [Google Scholar]
- Lei, X.; Zhao, R.; Geng, Y.; Wang, K.; Yang, P.O.; Chen, D.; Huang, X.; Zuo, Z.; He, C.; Chen, Z. Nocardia seriolae: A serious threat to the largemouth bass Micropterus salmoides industry in Southwest China. Dis. Aquat. Org. 2020, 142, 13–21. [Google Scholar] [CrossRef] [PubMed]
- Zhang, W.; Li, B.; Yu, R.; Xu, W.; Liu, X.; Su, J.; Yuan, G. Hepcidin contributes to largemouth bass (Micropterus salmoides) against bacterial infections. Int. J. Biol. Macromol. 2024, 266, 131144. [Google Scholar] [CrossRef] [PubMed]
- Wang, P.C.; Tsai, M.A.; Liang, Y.C.; Chan, Y.; Chen, S.C. Nocardia seriolae, a causative agent of systematic granuloma in spotted butterfish, Scatophagus argus, Linn. Afr. J. Microbiol. Res. 2014, 8, 38. [Google Scholar] [CrossRef]
- Kariya, T.; Kubota, S.; Nakamura, Y.; Kira, K. Nocardial infection in cultured yellowtails (Seriola quinqueruiata and S. purpurascens)—I. Fish Pathol. 1968, 3, 16–23. [Google Scholar] [CrossRef]
- Chen, S.C. Nocardiosis in sea bass, Lateolabrax japonicus, in Taiwan. J. Fish Dis. 2010, 23, 299–307. [Google Scholar] [CrossRef]
- Shimahara, Y.; Nakamura, A.; Nomoto, R.; Itami, T.; Chen, S.C.; Yoshida, T. Genetic and phenotypic comparison of Nocardia seriolae isolated from fish in Japan. J. Fish Dis. 2010, 31, 481–488. [Google Scholar] [CrossRef]
- Liu, Y.S.; Chen, G.Q.; Xia, L.Q.; Lu, Y.S. A review on the pathogenic bacterium Nocardia seriolae: Aetiology, pathogenesis, diagnosis and vaccine development. Rev. Aquacult. 2023, 15, 14–34. [Google Scholar] [CrossRef]
- Zhang, N.; Zhang, H.; Dong, Z.; Wang, W. Molecular Identification of Nocardia seriolae and Comparative Analysis of Spleen Transcriptomes of Hybrid Snakehead (Channa maculata Female × Channa argus Male) With Nocardiosis Disease. Front. Immunol. 2022, 13, 778915. [Google Scholar] [CrossRef]
- Huang, X.L.; Liu, S.; Chen, X.; Zhang, H.Q.; Yao, J.Y.; Geng, Y.; Ou, Y.P.; Chen, D.F.; Yin, L.Z.; Li, L.Y.; et al. Comparative pathological description of nocardiosis in largemouth bass (Micropterus salmoides) and other Perciformes. Aquaculture 2021, 534, 736193. [Google Scholar] [CrossRef]
- Odriguez, R.E.D.R.; Aredes, J.G.R.; Odriguez, S.A.S.; Shapira, Y.; Haydon, D.J. First evidence of fish nocardiosis in Mexico caused by Nocardia seriolae in farmed red drum (Sciaenops ocellatus, Linnaeus). J. Fish Dis. 2021, 44, 1117–1130. [Google Scholar] [CrossRef]
- Nguyen, P.; Giovanni, A.; Chen, L.W.; Chi, C. Pathogenicity characterization of nocardiosis in orange-spotted grouper (Epinephelus coioides) via exposure to nine distinct isolates of Nocardia seriolae and four administrative routes. J. Fish Dis. 2023, 46, 1257–1268. [Google Scholar] [CrossRef] [PubMed]
- Vu-Khac, H.; Duong, V.Q.; Chen, S.C.; Pham, T.H.; Nguyen, T.T.; Trinh, T.T. Isolation and genetic characterization of Nocardia seriolae from snubnose pompano Trachinotus blochii in Vietnam. Dis. Aquat. Org. 2016, 120, 173–177. [Google Scholar] [CrossRef] [PubMed]
- Bai, S.J.; Jian, Z.R.; He, S.Y.; Kuang, L.F.; Zhou, Z.Y.; Lu, C.W.; Zhong, Z.D.; He, J.; Xiong, Q.X.; Xiao, S.Y. The role of Nocardia seriolae-induced autophagy in the development of chronic inflammation in the liver and the formation of granulomas in largemouth bass (Micropterus salmoides). Aquaculture 2024, 592, 741157. [Google Scholar] [CrossRef]
- Zhou, Z.Y.; He, S.Y.; Lu, C.W.; Bai, S.J.; Kuang, L.F.; Yang, B.; Lian, S.; Jian, Z.R.; Wang, M.M.; Xiao, S.Y.; et al. Nocardia seriolae mediates granulomatous chronic inflammation of spleen in Micropterus salmoides through necroptosis. Aquaculture 2024, 580, 740360. [Google Scholar] [CrossRef]
- Akmal, M.; Araki, K.; Nishiki, I.; Yoshida, T. Isolation and Complete Genome Sequencing of NS-I, a Lytic Bacteriophage Infecting Fish Pathogenic Strains of Nocardia seriolae. Phage-Ther. Appl. Res. 2023, 4, 151–157. [Google Scholar] [CrossRef]
- Kupfer, M.; Kuhnert, P.; Korczak, B.M.; Peduzzi, R.; Demarta, A. Genetic relationships of Aeromonas strains inferred from 16S rRNA, gyrB and rpoB gene sequences. Int. J. Syst. Evol. Microbiol. 2006, 56, 2743–2751. [Google Scholar] [CrossRef]
- Kumar, V.; Abbas, A.K.; Aster, J.C. Robbins and Cotran Pathologic Basis of Disease, 10th ed.; Elsevier: Amsterdam, The Netherlands, 2020; p. 265. [Google Scholar]
- Wang, G.L.; Xu, Y.J.; Jin, S.; Zhu, J.L.; Yuan, S.P. Nocardiosis in snakehead, Ophiocephalus argus Cantor. Aquaculture 2007, 271, 54–60. [Google Scholar] [CrossRef]
- Ghasemieshkaftaki, M.; Vasquez, I.; Eshraghi, A.; Gamperl, A.K.; Santander, J. Comparative Genomic Analysis of a Novel Vibrio sp. Isolated from an Ulcer Disease Event in Atlantic Salmon (Salmo salar). Microorganisms 2023, 11, 1736. [Google Scholar] [CrossRef]
- Wang, J.; Wu, J.; Ma, Y.; Hao, L.; Huang, W.; Liu, Z.; Li, Y. Characterization of a membrane Fcγ receptor in largemouth bass (Micropterus saloumoides) and its response to bacterial challenge. Fish Physiol. Biochem. 2024, 50, 1123–1140. [Google Scholar] [CrossRef]
- Zhou, Z.Y.; Bai, S.J.; Lu, C.W.; Yang, B.; Wang, J.; Lian, S.; Jian, Z.R.; Wang, E.L.; Wang, G.X.; Liu, T. Nocardia seriolae mediates liver granulomatous chronic inflammation in Micropterus salmoides through pyroptosis. J. Fish Dis. 2024, 46, 321–332. [Google Scholar] [CrossRef]
- Toyohiro, N.; Ken-Ichi, W.; Motohiko, S. A Bath Challenge Method with Tenacibaculum maritimum for Japanese Flounder Paralichthys olivaceus. Fish Pathol. 2009, 44, 178–181. [Google Scholar] [CrossRef]
- Basak, C.; Chakraborty, R. Protocol to establish a disease model in Lepidocephalichthys guntea using Aeromonas hydrophila. STAR Protocols 2024, 5, 103165. [Google Scholar] [CrossRef] [PubMed]
- Kent, M.L.; Whipps, C.M.; Matthews, J.L.; Florio, D.; Watral, V.; Bishop-Stewart, J.K.; Poort, M.; Bermudez, L. Mycobacteriosis in zebrafish (Danio rerio) research facilities. Comp. Biochem. Phys. C 2004, 138, 383–390. [Google Scholar] [CrossRef] [PubMed]
- Ranger, B.S.; Mahrous, E.A.; Mosi, L.; Adusumilli, S.; Lee, R.E.; Colorni, A.; Rhodes, M.; Small, P.L.C. Globally Distributed Mycobacterial Fish Pathogens Produce a Novel Plasmid-Encoded Toxic Macrolide, Mycolactone F. Infect. Immun. 2006, 74, 6037. [Google Scholar] [CrossRef] [PubMed]
- Pate, M.; Jencic, V.; Zolnir-Dovc, M.; Ocepek, M. Detection of mycobacteria in aquarium fish in Slovenia by culture and molecular methods. Dis. Aquat. Org. 2005, 64, 29–35. [Google Scholar] [CrossRef]
- Hossam, A.; Iman, I.; Wes, B.; Lawrence, M.L.; Attila, K. Characterization of Histopathological and Ultrastructural Changes in Channel Catfish Experimentally Infected with Virulent Aeromonas hydrophila. Front. Mcrobiol. 2017, 8, 1519. [Google Scholar] [CrossRef]
- Iregui, C.A.; Guarin, M.; Tibata, V.M.; Ferguson, H.W. Novel brain lesions caused by Edwardsiella tarda in a red tilapia (Oreochromis spp.). J. Vet. Diagn. Investig. 2012, 24, 446–449. [Google Scholar] [CrossRef]
- Eletr, S.H.; Yan, L.; Cirillo, J.D. Fish Monocytes as a Model for Mycobacterial Host-Pathogen Interactions. Infect. Immun. 2001, 69, 7310–7317. [Google Scholar] [CrossRef]
- Gauthier, D.T.; Vogelbein, W.K.; Ottinger, C.A. Ultrastructure of Mycobacterium marinum granuloma in striped bass Morone saxatilis. Dis. Aquat. Org. 2004, 62, 121–132. [Google Scholar] [CrossRef]
- Gauthier, D.T.; Rhodes, M.W. Mycobacteriosis in fishes: A review. Vet. J. 2009, 180, 33–47. [Google Scholar] [CrossRef]

| Gene | Sequence (Sense) | Sequence (Antisense) | Amplicon Sizes (bp) |
|---|---|---|---|
| 16S rRNA | 5′-GAGCGGATAACAATTTCACAGG-3′ | 5′-CGCCAGGGTTTTCC CAGTCACGAC-3′ | 1500 |
| gyrB | 5′-GAAGTCATCATGACCGTTCTGCAY GCNGGNGGNAARTTYGA-3′ | 5′-AGCAGGGTACGGATGTGCGAGCCRT CNACRTCNGCRTCNGTCAT-3′ [17] | 1200 |
Disclaimer/Publisher’s Note: The statements, opinions and data contained in all publications are solely those of the individual author(s) and contributor(s) and not of MDPI and/or the editor(s). MDPI and/or the editor(s) disclaim responsibility for any injury to people or property resulting from any ideas, methods, instructions or products referred to in the content. |
© 2024 by the authors. Licensee MDPI, Basel, Switzerland. This article is an open access article distributed under the terms and conditions of the Creative Commons Attribution (CC BY) license (https://creativecommons.org/licenses/by/4.0/).
Share and Cite
Li, C.; Wang, W.; Wu, F.; Pu, H.; Liao, L. Pathological Progress of Two Types of Nodules in Micropterus salmoides Infected with Nocardia seriolae. Fishes 2024, 9, 515. https://doi.org/10.3390/fishes9120515
Li C, Wang W, Wu F, Pu H, Liao L. Pathological Progress of Two Types of Nodules in Micropterus salmoides Infected with Nocardia seriolae. Fishes. 2024; 9(12):515. https://doi.org/10.3390/fishes9120515
Chicago/Turabian StyleLi, Chengwei, Wenhui Wang, Fan Wu, Hao Pu, and Lei Liao. 2024. "Pathological Progress of Two Types of Nodules in Micropterus salmoides Infected with Nocardia seriolae" Fishes 9, no. 12: 515. https://doi.org/10.3390/fishes9120515
APA StyleLi, C., Wang, W., Wu, F., Pu, H., & Liao, L. (2024). Pathological Progress of Two Types of Nodules in Micropterus salmoides Infected with Nocardia seriolae. Fishes, 9(12), 515. https://doi.org/10.3390/fishes9120515
